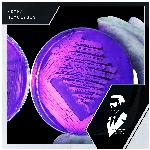

• singer• instrumental• Radio available
Edyra
0 followers 0 fans • Languages: instrumental, unknown, english
Popular
1
Hemolysis
Hemolysis
5 min 45 sec
2

Jos Te Sanjam
Jos Te Sanjam
5 min 37 sec
3

Follow Me
Follow Me
4 min 26 sec
4

Melanoma
Melanoma
4 min 39 sec
5

Pharaoh
Pharaoh
8 min 30 sec
6

Nymphetamine (Original Mix)
Nymphetamine
5 min 51 sec
7

Follow Me
Dance Land
4 min 26 sec
8

Follow Me
House Roots
4 min 26 sec
9

Melanoma
The Beautiful Music Series - Progressive House Moods Vol. 1
4 min 39 sec
10

Follow Me
Energizing Running Tracks
4 min 26 sec



